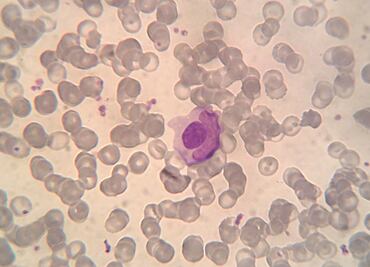

El lupus es una enfermedad crónica que inflama órganos y articulaciones, disminuyendo la capacidad de movimiento de quien la padece
El lupus es una enfermedad crónica que inflama órganos y articulaciones, disminuyendo la capacidad de movimiento de quien la padece

Además de los efectos físicos de la enfermedad, la cantante lucha contra la ansiedad, los ataques de pánico y la bipolaridad

Tras declaraciones de Trump, compras de pánico afectan a enfermos de lupus

Selena Gomez la ha pasado muy mal a causa del lupus que padece desde hace más de tres años

La conductora hizo un llamado sobre los altos costos de los medicamentos para enfermedades como la que padeció su hija

La actriz dedicó un video a Daniela, quien falleció a causa de lupus; tenía 31 años

Selena Gomez, Seal, Toni Brixton y Nick Cannon han sido diagnosticados; Kim Kardashian dio positivo a células

Daniela Santiago Sánchez padecía lupus desde hace varios años

Hay una gran cantidad de alimentos que se deberían evitar si padeces lupus

Daniela Santiago Sánchez padecía lupus desde hace varios años